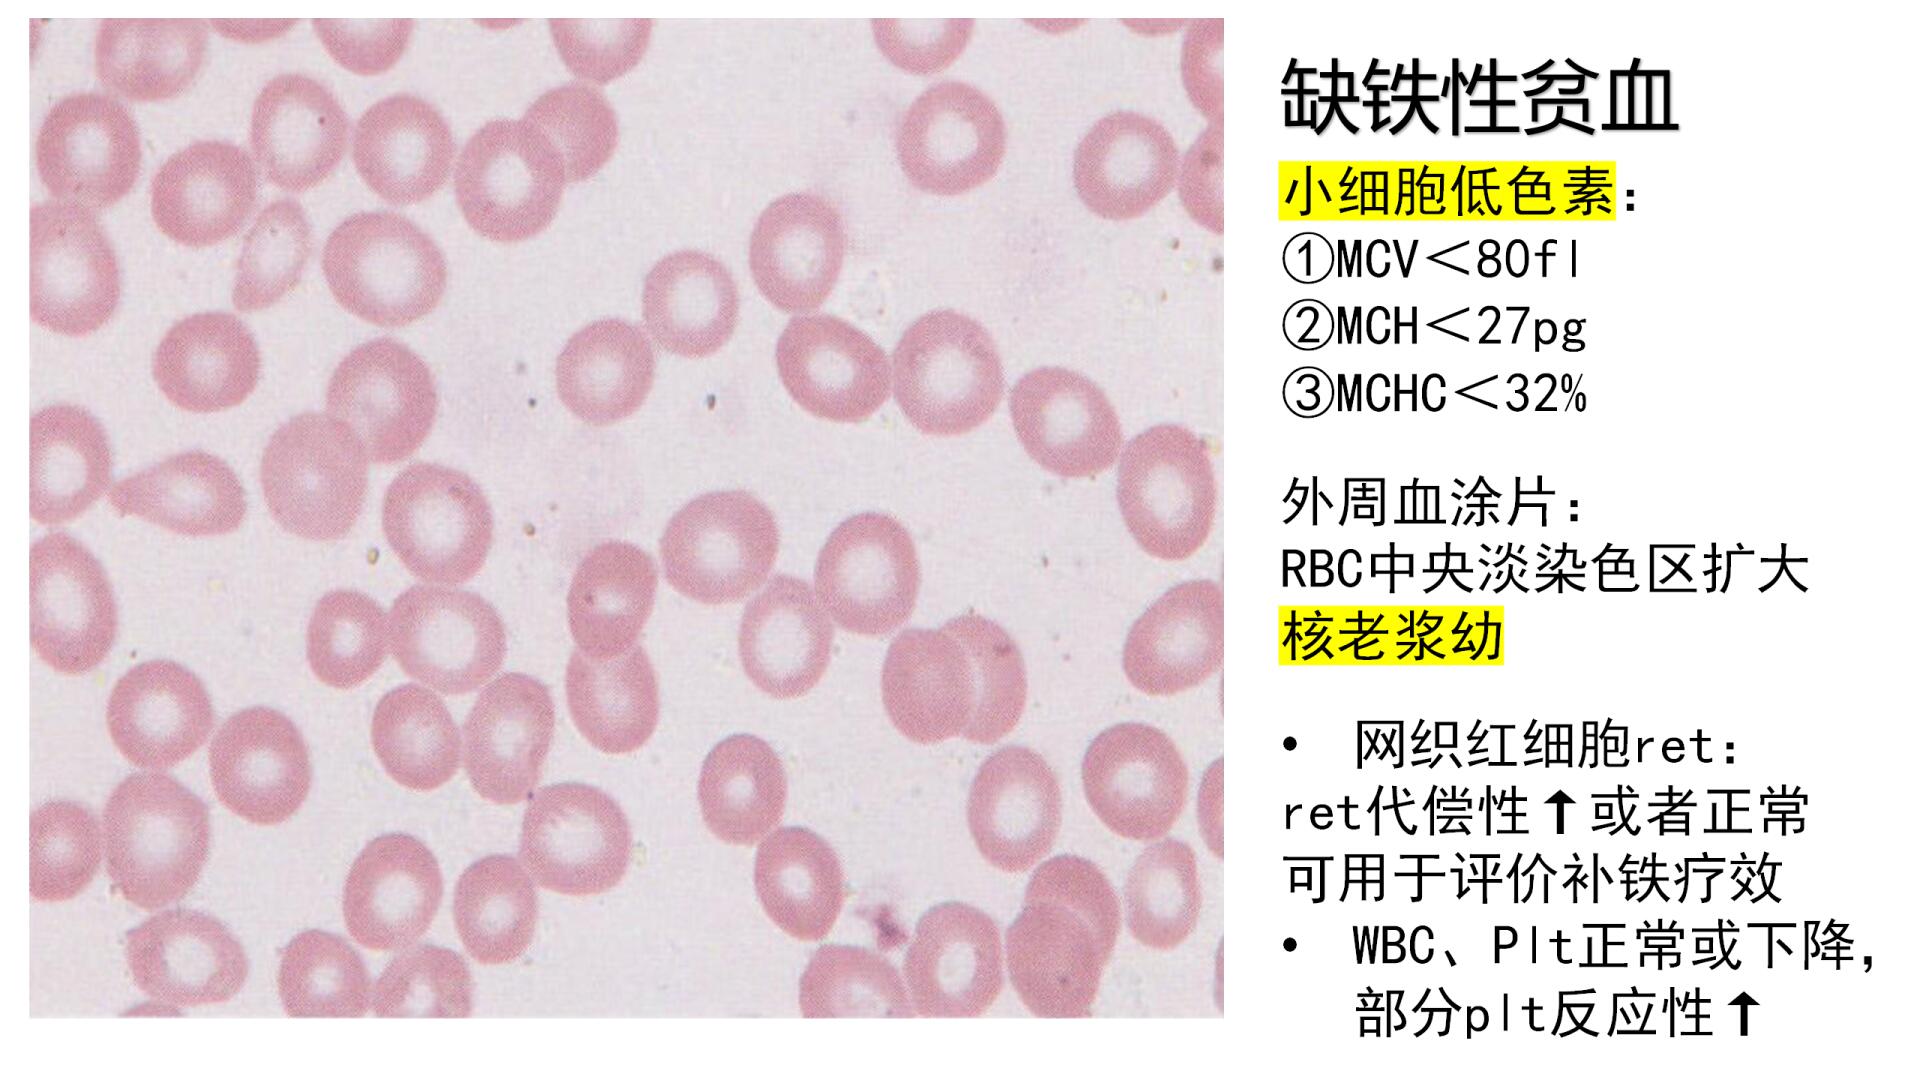

哎呀,说到缺铁性贫血的饮食调理,首先要记住"病从口入"这个理儿!平时改善饮食确实能帮大忙,比如多吃动物内脏、绿叶蔬菜这些含铁大户,西红柿和血制品也是补血小能手。不过光靠食补还不够,一定要配合医生开的药物,定期检查血色素水平才靠谱。贫血这事儿可马虎不得,得坚持治疗才能见效呢!

千万别喝茶:茶叶里的鞣酸会和铁元素结合形成不溶性物质,直接阻碍铁质吸收。这事儿可重要了,很多患者就是因为爱喝茶导致治疗效果打折扣,所以治疗期间最好暂时告别茶饮哦。
少碰牛奶:虽然牛奶营养丰富,但它的铁含量低得可怜,偏偏钙磷含量又高,容易和铁质结合成不易吸收的化合物。啧啧,这可是个隐藏的"铁质小偷",贫血患者喝牛奶要适量。
避开碱性食物:像馒头、荞麦面这类碱性食物会让胃环境变碱,不利于铁质吸收。要是本身胃酸不足的话,更会影响铁元素的转化,所以咱得注意饮食搭配。
腌制食品要不得:咸鱼、榨菜这些腌制品在加工过程中营养流失严重,不仅补不了铁,还可能加重贫血症状。哎呀,这些重口味的东西还是少吃为妙。
谷物要适量:虽然谷物是主食,但过量食用会影响铁吸收。建议搭配着肉类、蛋类、动物肝脏这些富铁食物一起吃,这样才能保证营养均衡。
缺铁性贫血喝咖啡有影响吗? 当然有影响啦!咖啡里的多酚类物质会和铁形成难溶的复合物,大大降低铁的吸收率。建议服药前后2小时内都不要喝咖啡,要不然药效可就打折扣了。平时要是实在想喝,最好安排在两餐之间,千万别跟着补铁食物或药物一起吃哦!
贫血患者可以吃海鲜吗? 海鲜可是个好东西!特别是贝类、牡蛎这些含铁量相当丰富,而且血红素铁吸收率特别高。不过要注意烹饪方式,清蒸、白灼最推荐,油炸的就要少碰啦。对了,海鲜最好搭配维生素C丰富的蔬菜一起吃,这样铁吸收效果会翻倍哦!
吃补铁食物要注意什么搭配? 这个特别关键!补铁最佳搭档是维生素C,比如吃完红肉来个橙子,铁吸收率能提高好几倍。但要避开茶、咖啡、牛奶这些"捣蛋鬼"。还有个小窍门:用铁锅炒菜也能悄悄补铁,老一辈传下来的方法确实有道理呢!
贫血好转后还要继续忌口吗? 哇,这是个好问题!症状好转后可以慢慢恢复正常饮食,但建议养成长期良好的饮食习惯。比如保持适量红肉摄入,定期吃动物肝脏,避免过量饮茶。毕竟预防重于治疗嘛,养成好习惯才能远离贫血困扰!
添加评论